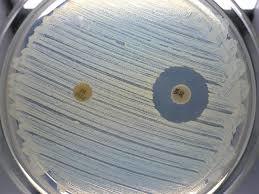
yjimageVQ065LP3.jpg

トレジャースマイル健康情報発信! 抗生物質について

抗生物質と聞くと私なら数年前、テレビで高視聴率を叩き出したドラマ「じん」の中で、南方先生が作り出してペニシリンのことを思い出します。
本来、ペニシリンは、1928年にイギリスのアレクサンダー・フレミングによって発見された世界初の抗生物質のことです。

この発見により、それまで難病とされていた、ペスト、梅毒、結核、肺炎などの患者が劇的に減らすことになった言わば、人類の「救世主薬」です。

最近の抗生物質では、おもに1.ペニシリン系抗生物質2.セフェム系抗生物質3.マクロライド系抗生物質4.テトラサイクリン系抗生物質5.ホスホマイシン系抗生物質6.アミノグリコシド系抗生物質7.ニューキノロン系抗菌剤その他多くの抗生物質が誕生しています。
これらのお陰で、今まで死の病とされていたものが死病ではなくなったことも事実です。
ところが、この無敵だと思われてきた抗生物質にも、抗生物質を多様したことで、逆にもっと強い菌、つまり切り札である抗生物質の効かない菌を生み出し、人類の脅威となっています。
メチシリン耐性黄色ブドウ球菌(MRSA),バンコマイシン耐性腸球菌(VRE)、多剤耐性緑膿菌(MDRP)・・・・などなど、そうしたやっかいな菌は、今も今後も更に形を変えて出てくることが予想されます。
この原因は、抗生物質なのです。 抗生物質は、体内にある素直な菌から死滅していきます、つまり体内に必要な菌まで殺してしまうことに問題があります。次に完全に菌を死滅させなかったせいで抗生物質からからくも逃げ切った菌が後に残りどんどん増殖して力をつける菌交代現象が体内で起こります。
医師より処方された、抗生物質は、途中で絶対服用を止めずに一度飲み始めたら5時間置きに最後まで飲みきりましょう!
腸内には、100兆を超える程の菌がいますので当然と言えば当然の成り行きかもしれませんね。
私達人類の歴史は、たかだか4~500万年、いっぽう細菌は、などの歴史は40億年余りにもなるのですから、抗生物質を発見したくらで細菌との戦いに勝利したと勘違いすることはばかげた事です。

昨夜のニュースでハリウッドスターのチャーリーシーン(50)が自らHIV陽性だということを告白して大きな話題になっていますが恐ろしいのは、自らHIV感染者としてわかった上で多くの異性の性交渉していたことです。
バイオハザードの現実版が近い将来起こるとしても不思議ではありません。
現代社会において、個人レベルでの免疫力は、生活習慣病の代表されるようにどんどん低下し、社会レベルでは、抗生物質が効かないエボラ菌の様な菌やウイルスがますます増える結果となるのは、今後の課題であり、急ピッチで対応していかないといけない問題です。

世界中が軍事費に予算を大幅に削り、医療革新に予算を組み替えない限り地球の未来は危ぶまれます。
少なくても我々は、自らで自らを守る知恵だけは養っていかねばならないと思うところです。

まずは、薬は、どんな薬でも副作用も必ず伴うということを頭にいれて、服用する際は十分過ぎるくらい慎重にお願いします。併せて、薬のいらない体づくりを目指して参りましょう!
トレジャースマイルでは、免疫力を上げる為のサポート健康食品を取り揃えております。
日頃より、体調を崩し易い方、難病でお悩みの人は、一度ご検討下さい!
http://www.rakuten.ne.jp/gold/toresuma/

抗生物質と聞くと私なら数年前、テレビで高視聴率を叩き出したドラマ「じん」の中で、南方先生が作り出してペニシリンのことを思い出します。
本来、ペニシリンは、1928年にイギリスのアレクサンダー・フレミングによって発見された世界初の抗生物質のことです。
この発見により、それまで難病とされていた、ペスト、梅毒、結核、肺炎などの患者が劇的に減らすことになった言わば、人類の「救世主薬」です。

最近の抗生物質では、おもに1.ペニシリン系抗生物質2.セフェム系抗生物質3.マクロライド系抗生物質4.テトラサイクリン系抗生物質5.ホスホマイシン系抗生物質6.アミノグリコシド系抗生物質7.ニューキノロン系抗菌剤その他多くの抗生物質が誕生しています。
これらのお陰で、今まで死の病とされていたものが死病ではなくなったことも事実です。
ところが、この無敵だと思われてきた抗生物質にも、抗生物質を多様したことで、逆にもっと強い菌、つまり切り札である抗生物質の効かない菌を生み出し、人類の脅威となっています。
メチシリン耐性黄色ブドウ球菌(MRSA),バンコマイシン耐性腸球菌(VRE)、多剤耐性緑膿菌(MDRP)・・・・などなど、そうしたやっかいな菌は、今も今後も更に形を変えて出てくることが予想されます。
この原因は、抗生物質なのです。 抗生物質は、体内にある素直な菌から死滅していきます、つまり体内に必要な菌まで殺してしまうことに問題があります。次に完全に菌を死滅させなかったせいで抗生物質からからくも逃げ切った菌が後に残りどんどん増殖して力をつける菌交代現象が体内で起こります。
医師より処方された、抗生物質は、途中で絶対服用を止めずに一度飲み始めたら5時間置きに最後まで飲みきりましょう!
腸内には、100兆を超える程の菌がいますので当然と言えば当然の成り行きかもしれませんね。
私達人類の歴史は、たかだか4~500万年、いっぽう細菌は、などの歴史は40億年余りにもなるのですから、抗生物質を発見したくらで細菌との戦いに勝利したと勘違いすることはばかげた事です。

昨夜のニュースでハリウッドスターのチャーリーシーン(50)が自らHIV陽性だということを告白して大きな話題になっていますが恐ろしいのは、自らHIV感染者としてわかった上で多くの異性の性交渉していたことです。
バイオハザードの現実版が近い将来起こるとしても不思議ではありません。
現代社会において、個人レベルでの免疫力は、生活習慣病の代表されるようにどんどん低下し、社会レベルでは、抗生物質が効かないエボラ菌の様な菌やウイルスがますます増える結果となるのは、今後の課題であり、急ピッチで対応していかないといけない問題です。

世界中が軍事費に予算を大幅に削り、医療革新に予算を組み替えない限り地球の未来は危ぶまれます。
少なくても我々は、自らで自らを守る知恵だけは養っていかねばならないと思うところです。

まずは、薬は、どんな薬でも副作用も必ず伴うということを頭にいれて、服用する際は十分過ぎるくらい慎重にお願いします。併せて、薬のいらない体づくりを目指して参りましょう!
トレジャースマイルでは、免疫力を上げる為のサポート健康食品を取り揃えております。
日頃より、体調を崩し易い方、難病でお悩みの人は、一度ご検討下さい!
http://www.rakuten.ne.jp/gold/toresuma/